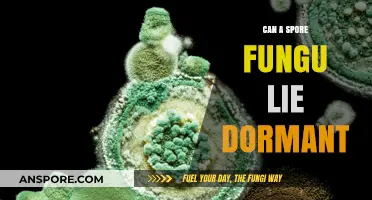
Can Spore Fungi Lie Dormant? Unveiling Their Survival Secrets

The question of whether a spore syringe can contaminate between uses is a critical concern for mycologists, hobbyists, and researchers working with fungi. Spore syringes are commonly used to propagate mushrooms by dispersing spores into a substrate, but improper handling or storage can introduce contaminants, compromising the entire cultivation process. Contamination risks arise from factors such as inadequate sterilization, exposure to airborne particles, or the introduction of foreign microorganisms during use. Understanding the potential for contamination and implementing strict aseptic techniques, such as using sterile equipment and working in a clean environment, are essential to mitigate these risks and ensure successful fungal cultivation.
Explore related products
What You'll Learn

Spore Viability Post-Exposure
Spores, renowned for their resilience, can survive harsh conditions, but their viability post-exposure to contaminants is a critical concern. When a spore string (a chain of spores) is exposed to contaminants between uses, the integrity of each spore is tested. For instance, in laboratory settings, spore strings used in viability assays must be handled with precision to avoid cross-contamination. A single contaminant, such as a chemical residue or microbial intruder, can compromise the entire string, rendering the spores non-viable for future use. This highlights the importance of sterile techniques and controlled environments in maintaining spore viability.
Analyzing the factors affecting spore viability post-exposure reveals a delicate balance. Temperature, humidity, and exposure duration play pivotal roles. For example, spores exposed to temperatures above 60°C for more than 10 minutes may lose viability due to protein denaturation. Similarly, high humidity levels can activate spores prematurely, leading to germination and subsequent death if nutrients are absent. Practical tips include storing spore strings in desiccated conditions at 4°C and minimizing exposure time to potential contaminants. These measures ensure that spores remain dormant and viable until intentional activation.
From a comparative perspective, different spore types exhibit varying resistance to contaminants. *Bacillus subtilis* spores, commonly used in sterilization validation, can withstand higher levels of chemical exposure compared to *Clostridium botulinum* spores. This disparity underscores the need for species-specific protocols when handling spore strings. For instance, while *B. subtilis* spores may tolerate brief exposure to ethanol, *C. botulinum* spores require more stringent protection. Understanding these differences allows for tailored strategies to preserve spore viability post-exposure.
Instructive guidelines for preventing contamination focus on proactive measures. First, sterilize all tools and surfaces using autoclaving or 70% ethanol wipes before handling spore strings. Second, use laminar flow hoods to create a sterile workspace, reducing airborne contaminants. Third, limit the number of times a spore string is exposed to the environment; each exposure increases contamination risk. For example, if a spore string is used for testing, immediately return it to a sealed, sterile container rather than leaving it exposed. These steps minimize the likelihood of contaminants compromising spore viability.
Persuasively, the economic and scientific implications of maintaining spore viability cannot be overstated. In industries like pharmaceuticals and food safety, contaminated spore strings can lead to inaccurate test results, product recalls, and financial losses. For instance, a single contaminated batch of spores used in sterilization validation could result in faulty medical equipment reaching patients. By prioritizing meticulous handling and storage practices, organizations can safeguard spore viability, ensuring reliable outcomes and upholding public safety standards. This diligence transforms a technical detail into a cornerstone of quality control.
How Long Do Ringworm Spores Survive: A Comprehensive Guide
You may want to see also

Contamination Risks During Storage
Spores, by their very nature, are resilient structures designed to survive harsh conditions, making them formidable contaminants if not handled properly. During storage, the risk of contamination arises not just from the spores themselves but from the interplay of environmental factors and storage practices. For instance, spore strips used in sterilization monitoring must be stored in cool, dry conditions to prevent moisture absorption, which can activate spores prematurely. Even a slight increase in humidity—above 60%—can compromise their integrity, leading to false results in sterilization tests.
Consider the storage of spore vials in laboratories or medical facilities. These vials, often containing *Bacillus atrophaeus* or *Geobacillus stearothermophilus*, require precise temperature control (2–8°C) to remain dormant. Exposure to temperatures above 25°C for more than 24 hours can trigger germination, rendering the spores unusable for testing. Additionally, improper sealing of vials or exposure to airborne contaminants can introduce foreign microorganisms, defeating the purpose of using spores as a control.
A comparative analysis of storage containers reveals that glass vials with silicone seals outperform plastic containers in maintaining sterility. Glass is non-porous and less prone to degradation, while silicone seals provide an airtight barrier against moisture and particulate matter. In contrast, plastic containers may leach chemicals or degrade over time, especially when exposed to UV light or temperature fluctuations. For long-term storage, vacuum-sealed packaging or desiccant-lined containers can further reduce contamination risks by minimizing oxygen and moisture exposure.
Practical tips for minimizing contamination include labeling storage containers with expiration dates and handling instructions, as well as regularly inspecting storage areas for signs of mold, dust, or temperature inconsistencies. For spore strips, storing them in their original packaging until immediate use is critical, as opening the packaging prematurely exposes them to environmental hazards. Facilities should also implement a first-in, first-out (FIFO) system to ensure older stock is used before newer batches, reducing the likelihood of expired or compromised materials.
Ultimately, the key to preventing contamination during storage lies in vigilance and adherence to strict protocols. By understanding the vulnerabilities of spores and implementing targeted storage practices, users can maintain the integrity of these critical tools, ensuring reliable results in sterilization validation and microbial control.
Are Mushroom Spores Legal in Canada? Understanding the Current Laws
You may want to see also

Effectiveness of Sterilization Methods
Spores, particularly those of *Clostridium difficile* and *Bacillus* species, are notorious for their resilience against standard disinfection methods. Their ability to persist on surfaces and instruments between uses poses a significant contamination risk in medical, laboratory, and industrial settings. Sterilization methods must therefore be rigorously evaluated for their efficacy against these hardy organisms.
Analytical Perspective:
The effectiveness of sterilization methods hinges on their ability to penetrate spore coats and disrupt DNA or cellular structures. Autoclaving, the gold standard, uses saturated steam at 121°C for 15–30 minutes or 134°C for 3–10 minutes, achieving a 6-log10 reduction in spore viability. However, dry heat sterilization (160°C for 2 hours) is less efficient due to uneven heat distribution, often requiring longer cycles. Chemical methods, such as hydrogen peroxide gas plasma (5.6–7.2 log10 reduction) or peracetic acid (40–50°C for 10–20 minutes), are effective but require precise application to avoid residue or equipment damage.
Instructive Approach:
To ensure spore eradication between uses, follow these steps: (1) Clean instruments thoroughly to remove organic debris, which can shield spores. (2) Use a validated sterilization cycle; for autoclaves, verify temperature, pressure, and cycle time. (3) Employ biological indicators (e.g., *Geobacillus stearothermophilus* spores) to confirm efficacy. (4) Store sterilized items in sealed containers to prevent recontamination. For chemical methods, ensure proper ventilation and follow manufacturer guidelines for concentration and exposure time.
Comparative Analysis:
While autoclaving remains the most reliable method, alternatives like ethylene oxide (EtO) gas offer advantages for heat-sensitive materials. EtO achieves sterilization at 37–63°C with 4–8 hours of exposure but requires aeration to remove toxic residues. In contrast, UV-C light (254 nm) is ineffective against spores due to its inability to penetrate their thick coats. Emerging technologies, such as cold atmospheric plasma, show promise but lack standardized protocols for spore inactivation.
Persuasive Argument:
Investing in robust sterilization methods is not optional—it’s a critical safeguard against outbreaks. A single surviving spore can multiply rapidly under favorable conditions, leading to infections like *C. difficile* colitis or anthrax. Facilities must prioritize validated techniques, regular monitoring, and staff training to mitigate risks. Cutting corners on sterilization protocols jeopardizes patient safety and operational integrity.
Descriptive Insight:
Imagine a surgical instrument contaminated with *Bacillus* spores. After a routine clean, it appears sterile but harbors dormant spores. Without proper sterilization, these spores germinate upon contact with nutrients, colonizing the next patient. This scenario underscores the invisible threat spores pose and the necessity of methods like autoclaving or vaporized hydrogen peroxide to break their resilience. Only through meticulous application can we ensure a contamination-free environment.
Are Mold Spores Harmful? Understanding Health Risks and Prevention Tips
You may want to see also
Explore related products

Cross-Contamination Between Uses
Spores, by their very nature, are resilient structures designed to survive harsh conditions, making them formidable contaminants in various settings. When considering the risk of cross-contamination between uses, especially in environments like laboratories, healthcare facilities, or even home fermentation setups, the durability of spores becomes a critical concern. For instance, *Clostridium difficile* and *Bacillus anthracis* spores can remain viable on surfaces for months, posing a persistent threat if not properly managed. This resilience underscores the necessity of rigorous decontamination protocols to prevent unintended spread.
To mitigate cross-contamination, a multi-step approach is essential. First, thorough cleaning with detergent or soap is required to remove organic matter that shields spores from disinfectants. Second, chemical disinfection using spore-specific agents like chlorine bleach (5,000–10,000 ppm) or hydrogen peroxide (7.5% solution) is crucial. For example, in healthcare settings, surfaces contaminated with *C. difficile* spores are treated with a 1:10 bleach solution for 10 minutes. Third, physical removal through practices like autoclaving (121°C for 30 minutes) or incineration ensures complete destruction of spores. Skipping any of these steps can leave spores viable, increasing the risk of contamination during subsequent use.
A comparative analysis of spore behavior highlights why cross-contamination is particularly challenging. Unlike vegetative bacteria, spores resist heat, desiccation, and many disinfectants due to their thick protein coat and low water content. For instance, while ethanol effectively kills most bacteria, it is ineffective against spores. This distinction necessitates tailored strategies for spore deactivation. In contrast, viruses, which lack a cellular structure, are generally more susceptible to disinfectants, making spore management uniquely demanding. Understanding these differences is key to designing effective contamination prevention plans.
Practical tips for preventing cross-contamination focus on workflow design and material handling. In laboratory settings, designate separate areas for spore-related work and use single-use tools or sterilize reusable equipment between uses. For home fermenters, avoid using the same utensils for different batches without proper sterilization. For example, a pressure cooker can sterilize jars and tools at 15 psi for 15 minutes. Additionally, personal protective equipment (PPE), such as gloves and lab coats, should be changed or disinfected between tasks to prevent mechanical transfer of spores. These measures, while seemingly small, significantly reduce the risk of cross-contamination.
Finally, the takeaway is clear: spores’ ability to persist and resist common decontamination methods makes them a unique challenge. Cross-contamination between uses is not just possible but likely without strict adherence to protocols. By combining mechanical cleaning, chemical disinfection, and physical destruction, along with thoughtful workflow practices, the risk can be minimized. Whether in a professional or home setting, vigilance and education are paramount to ensuring safety and preventing unintended spore spread.
Eukaryotic Decomposers: Spore Reproduction and Their Vital Ecological Role
You may want to see also

Impact of Environmental Factors
Environmental factors play a pivotal role in determining whether a spore syringe can become contaminated between uses. Temperature fluctuations, for instance, can compromise the integrity of the syringe’s contents. Spores are resilient, but prolonged exposure to temperatures above 30°C (86°F) or below 4°C (39°F) can weaken their protective barriers, making them more susceptible to contamination. Similarly, humidity levels matter; high humidity (above 70%) can encourage the growth of unwanted microorganisms, while low humidity (below 30%) may dry out the syringe’s contents, reducing viability.
Light exposure is another critical factor often overlooked. Spores stored in clear syringes are particularly vulnerable to UV light, which can degrade their genetic material over time. To mitigate this, always store spore syringes in opaque containers or wrap them in aluminum foil. Additionally, air quality cannot be ignored. Spores exposed to airborne contaminants, such as dust or mold spores, are at higher risk of cross-contamination. Using a HEPA filter in the storage area can significantly reduce this risk, especially in environments prone to particulate matter.
The material of the syringe itself interacts with environmental factors in unexpected ways. Plastic syringes, while common, can leach chemicals when exposed to heat or certain solvents, potentially harming the spores. Glass syringes, though more expensive, offer better resistance to temperature changes and chemical interactions. Always ensure the syringe is made of inert materials and is sealed with a sterile Luer lock cap to minimize environmental interference.
Practical steps can be taken to counteract these environmental risks. First, maintain a stable storage temperature between 15°C and 20°C (59°F–68°F) using a dedicated refrigerator or cool, dark cabinet. Second, use desiccant packs to control humidity in storage containers, replacing them monthly. Third, label syringes with the date of first use and discard any that have been open for more than 30 days, as prolonged exposure to environmental factors increases contamination risk. By addressing these specifics, users can significantly extend the shelf life and reliability of spore syringes.
Are Moss Spores Identical? Unveiling the Diversity in Moss Reproduction
You may want to see also
Frequently asked questions
Yes, a spore string can potentially contaminate in between uses if not properly sterilized or handled, as spores can harbor microorganisms that may spread.
To prevent contamination, thoroughly sterilize the spore string using heat (e.g., autoclaving) or disinfectant solutions, and store it in a clean, dry environment.
No, reusing a spore string without proper sterilization increases the risk of contamination, as residual spores or microorganisms may remain on the surface.
Sterilize the spore string before and after each use to minimize the risk of contamination and ensure it remains free of harmful microorganisms.
Yes, a contaminated spore string can compromise the accuracy of spore testing by introducing unwanted microorganisms, leading to false results or unreliable data.







![KwikSafety - Charlotte, NC - TAIPAN 6’ Double Leg Flat Safety Lanyard [Safety Anchor Combo] ANSI Tested OSHA Compliant Adjustable Fall Restraint Protection Construction Roofing Beam Equipment](https://m.media-amazon.com/images/I/810ARRDiu+L._AC_UL320_.jpg)